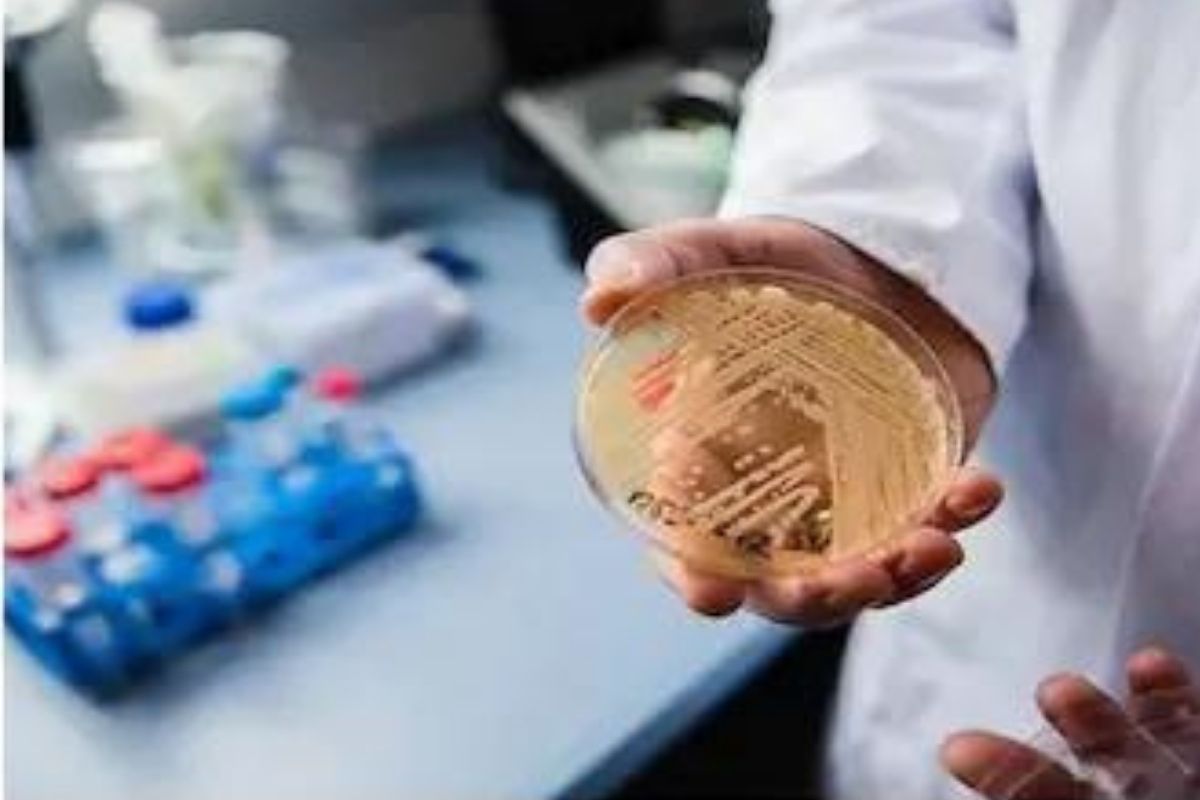
नवं संकट! Candida auris चे रुग्ण आढळल्यानं खळबळ; उपचारही उपलब्ध नसल्यानं चिंता वाढली

नवी दिल्ली 24 जुलै : जगावरचं कोरोनाचं संकट अजूनही पूर्णपणे टळलं नाही. अमेरिकेमध्ये पूर्ण लसीकरण झालेल्या नागरिकांना मास्क वापरण्यापासून काही दिवसांपूर्वीच सूट देण्यात आली होती. यामुळे लोकांना काही प्रमाणात दिलासा मिळाला असला, तरी आता अमेरिकेत एक नवीन संकट समोर आलं आहे. अमेरिकेत आता कँडिडा ऑरिस (Candida auris) नावाच्या बुरशीची (Fungus) लागण काही जणांना झाल्याचं समोर आलं आहे. ‘TV9 हिंदी’ने याबाबतचं वृत्त दिलं आहे. अमेरिकेतल्या आरोग्य विभागाच्या अधिकाऱ्यांनी गुरुवारी डल्लासमधल्या (Dallas) दोन रुग्णालयांत आणि वॉशिंग्टन डीसीमधल्या (Washington DC) एका नर्सिंग होममध्ये या फंगसचे रुग्ण आढळून आल्याची माहिती दिली. कँडिडा ऑरिस हे यीस्टचं एक गंभीर रूप आहे. या फंगसची लागण झाल्यामुळे मृत्यूही होऊ शकतो. आधीपासून इतर गंभीर आजार असणाऱ्यांना या फंगसची लागण झाल्यास मृत्यूचा धोका अधिक असतो. Pfizer लस अखेर ‘या’ महिन्यात भारताला मिळणार; सरकारची कंपनीबरोबर चर्चा सुरू वॉशिंग्टन डीसीमधल्या नर्सिंग होममध्ये कँडिडा ऑरिसचे 101 रुग्ण आढळून आले आहेत. डल्लासमधल्या रुग्णालयात 22 रुग्णांना या फंसगची लागण झाल्याचं दिसून आलं आहे. वॉशिंग्टनमधले तीन रुग्ण असे होते, की ज्यांच्यावर तीन प्रकारच्या अँटीफंगल औषधांचा (Anti-Fungal drugs) परिणाम झाला नाही. डल्लासमध्येही असे दोन रुग्ण आढळून आले. यूएस सेंटर फॉर डिसीज कंट्रोल अँड प्रिव्हेन्शनने (CDC) दिलेल्या माहितीनुसार, या फंगसची लागण झालेल्या तीनपैकी एकाहून अधिक रुग्णांचा मृत्यू होतो. अमेरिकेच्या आरोग्य संस्थेने या फंगसला जागतिक धोका म्हणून जाहीर केलं आहे. कित्येक अँटीफंगल औषधांचा यावर काहीच परिणाम होत नसल्यामुळे वैद्यकीय तज्ज्ञ चिंतित आहेत. यासोबतच रुग्णांवर उपचार करण्याआधी तपासणीमध्ये या फंगसची योग्य ओळख केली जाणं आवश्यक आहे. कारण, चुकीची ओळख केली गेली तर चुकीचे उपचार केला जाण्याचा धोका असतो. सीडीसीच्या (CDC) मेगन रयान यांनी सांगितलं, की एका रुग्णामधून दुसऱ्या रुग्णामध्ये संसर्ग होणारा कँडिडा ऑरिस क्लस्टर पहिल्यांदाच आढळला आहे. या फंगसवर अद्याप उपचार उपलब्ध नाहीत. Zydus Cadila च्या कोरोना लशीला देशात लवकरच मिळणार परवानगी? ही आहेत वैशिष्ट्यं सीडीसीने दिलेल्या माहितीनुसार, ताप येणं आणि थंडी वाजणं ही कँडिडा ऑरिसची लागण झाल्याची लक्षणं आहेत. (Candida auris symptoms) अँटिबायोटिक उपचारांनंतरही ही लक्षणं कायम राहतात. आतापर्यंत ज्या लोकांना या फंगसची लागण झाली आहे, त्यांना आधीपासूनच इतर आजार होते. त्यामुळे कँडिडा ऑरिसची लागण कोणाला झाली आहे त्याची खातरजमा करणं अवघड होतं. कँडिडा ऑरिसची लागण झालेल्या रुग्णांवर कोणत्याही अँटीफंगल औषधांचा परिणाम का होत नाही याबाबत शास्त्रज्ञ संशोधन करत आहेत. तसंच, आताच हे फंगस का पसरत आहे, याचाही शोध सुरू आहे.
मराठी बातम्या, ब्रेकिंग न्यूज मराठीत सर्वात आधी News18 लोकमतवर. आजच्या ताज्या बातम्या, लाइव्ह न्यूज अपडेट, सर्वात आधी वाचा विश्वासार्ह मराठी न्यूज वेबसाइट News18 लोकमतवर.
)







